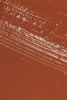
EM Cosmetics FADED CLEMENTINE

Description
Faded Clementine is a soft tangerine. DETAILS Were giving you the shine of a 90s lip gloss, without the uncomfortable sticky texture. This gel-based formula gives you a lacquer-like shine, while subtly plumping and drenching your lips in a high-impact color. FEATURES + BENEFITS Advanced gel base maintains the wet-like shine. A lip-plumping peptide complex helps stimulate collagen production while giving the appearance of smoother, fuller lips (you may experience a slight tingle) Vitamin C, Vitamin E, and emollients help keep lips feeling soft, conditioned, and comfortable Essential fatty acids help to hydrate and replenish Cruelty-free GE Glide on using applicator. Reapply as desired. PRO-TIPS Prep your lips: For the smoothest application, gently exfoliate with a lip scrub. For precise application, outline your lips using the point of the petal applicator, then fill in. Layer over a liquid lip to add multi-dimensional shine. CLAIMS Cruelty Free No PFAs/PFOs PaGREDIENTS 4 ml / 0.13 fl. oz. Paraffinum Liquidum [Mineral Oil], Ethylhexyl Palmitate, Pentaerythrityl Tetraisostearate, Silica Dimethyl Silylate, Ethylene/Propylene/Styrene Copolymer, Butylene/Ethylene/Styrene Copolymer, Mica, Calcium Sodium Borosilicate, Tocopheryl Acetate, Lecithin, Tocopherol, Ascorbyl Palmitate, Citric Acid, Octocrylene, Tribehenin, Sorbitan Isostearate, Palmitoyl Tripeptide-1, Decylene Glycol, Phenoxyethanol, Tropolone, Tin Oxide, Aroma (Flavour). May Contain:Ci 77891 (Titanium Dioxide), Ci 77491 (Iron Oxides), Ci 77492 (Iron Oxides), Ci 77499 (Iron Oxides), Ci 77742 (Manganese Violet), Ci 42090 (Blue 1 Lake), Ci 19140 (Yellow 5 Lake), Ci 75470 (Carmine), Ci 15850 (Red 7 Lake), Ci 15850 (Red 6 ).
Country of Origin: USA
Manufacturer/Importer/Packed By: EM Cosmetics
Country of Origin: USA
Manufacturer/Importer/Packed By: EM Cosmetics